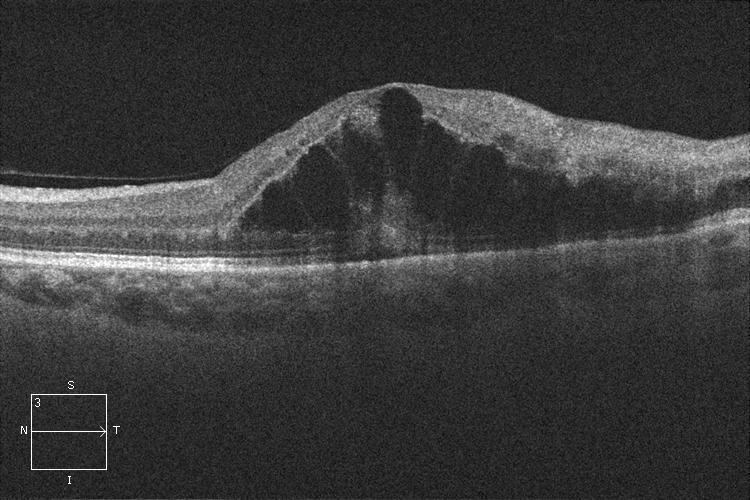
fullwidth image
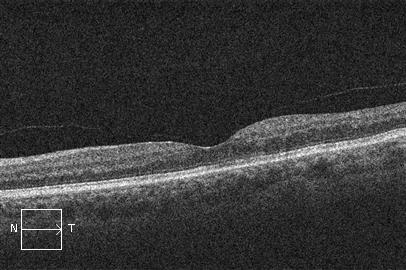
fullwidth image

Oclusión venosa retiniana
¿Qué es la oclusión o trombosis venosa retiniana?
La oclusión o trombosis venosa retiniana es la consecuencia directa de una obstrucción a nivel de la circulación venosa de la retina.
Cuando la obstrucción venosa tiene lugar en el nervio óptico se produce una oclusión de la vena central de la retina. Si la obstrucción tiene lugar en un cruce arteriovenoso de la retina se produce una oclusión de rama venosa retiniana.
¿Por qué se produce una oclusión o trombosis venosa retiniana?
La oclusión venosa retiniana es una enfermedad frecuente que afecta principalmente a la gente mayor con factores de riesgo vasculares (hipertensión, colesterol, diabetes, tabaco) o con una presión ocular elevada (glaucoma).
¿Qué síntomas tiene una persona con una oclusión o trombosis venosa retiniana?
Una oclusión venosa retiniana que afecta la parte central de la retina (mácula) produce una pérdida brusca, importante e indolora de la visión.
¿Cómo se diagnostica una oclusión o trombosis venosa retiniana?
El diagnóstico de una oclusión o trombosis venosa retiniana se realiza con un examen del fondo del ojo donde el oftalmólogo verá los signos clínicos característicos de la enfermedad.
La angiografía con fluoresceína es una prueba complementaria que permite distinguir entre las oclusiones venosas isquémicas y no isquémicas y determinará si es necesario hacer láser.
La OCT (tomografía de coherencia óptica) permite valorar la presencia y grado de inflamación en la zona central de la retina (edema macular).
¿Cómo se trata una oclusión o trombosis venosa retiniana?
El control y tratamiento de los factores de riesgo vasculares son fundamentales para prevenir nuevos episodios de trombosis venosa retiniana en el mismo ojo o en el ojo contralateral.
En el caso de una oclusión venosa retiniana isquémica debe realizarse una fotocoagulación retiniana con láser para prevenir la aparición de complicaciones oculares como el glaucoma neovascular.
Si existe inflamación de la parte central de la retina (edema macular) está indicado el tratamiento con inyecciones intravítreas de antiangiogénicos o antinflamatorios (corticoides).
OCT. Edema macular por oclusión venosa retiniana antes del tratamiento